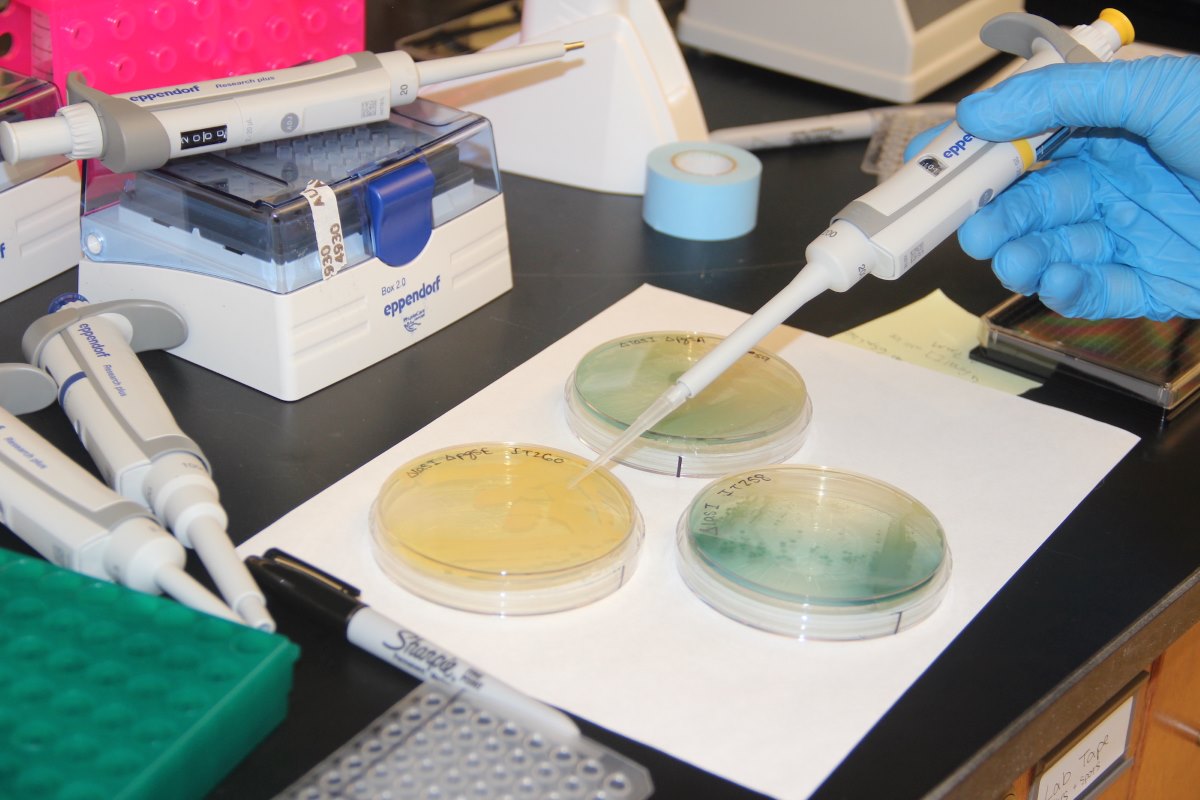

- This event has passed.
What Do Bacteria Talk About? Exploring New Ways to Treat Bacterial Infections (WL)
Bacterial resistance to antibiotics is a growing concern. Learn about research seeking new ways to treat bacterial infections. Jesse Derringer, master’s student in Chemistry at William & Mary, will explain how his lab targets a particular cellular process—bacterial communication, or quorum sensing—to disrupt bacteria when killing them with traditional antibiotics becomes impossible. Understanding quorum sensing will produce alternative treatments for people suffering with a difficult-to-treat infections. This talk will demystify current approaches to combating infection and showcase the complexity of bacteria.
The Emerging Scholars Series is a partnership between the Arts & Sciences Graduate Center at William & Mary and the Williamsburg Regional Library. The series features W&M graduate students and postdocs in talks hosted by the WRL intended to bring cutting-edge research to the local community.
Emerging Scholars is an exciting ongoing series highlighting the latest research on a variety of topics coming out of William & Mary’s graduate programs in Arts & Sciences.
